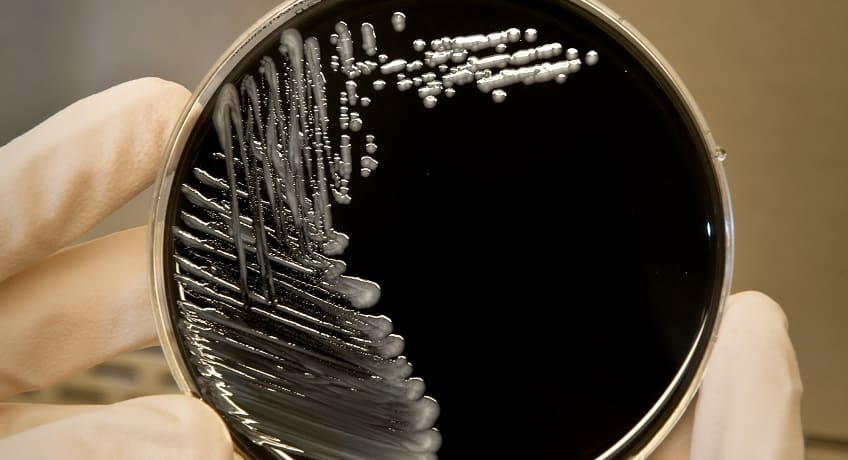

La natamicina (nota anche come pimaricina) è un composto organico usato in medicina umana contro le infezioni fungine e come agente antimicotico nell’industria alimentare.
Un recente studio, condotto dal dottor Chang He della Chinese Academy of Sciences, ha dimostrato che l’applicazione di natamicina in postraccolta può avere un forte effetto inibitorio sulla crescita di due importanti funghi patogeni come Botrytis cinerea e Penicillium expansum.
Secondo il lavoro di ricerca, l’applicazione di 100 mg/l inibisce completamente l’insorgenza di muffe grigie sugli acini di uva, mentre 200 /l sono necessari per controllare le infezioni di Penicillium.
L’effetto inibitorio della natamicina sul processo di infezione è principalmente dovuto alla sua azione diretta sulla germinazione delle spore.
Per indagare ulteriormente i meccanismi con cui la natamicina inibisce la crescita dei funghi, è stata valutata l’integrità della loro membrana plasmatica. I risultati hanno indicato che la natamicina può danneggiare la membrana plasmatica dei patogeni, causando il rilascio di contenuto intracellulare e quindi la morte delle cellule.
I risultati suggeriscono che questo composto ha un’alta efficienza nel controllo di questi patogeni in postraccolta. Inoltre, la bassa tossicità e l’ampio spettro antimicrobico, potrebbero consentire alla natamicina di diventare una valida alternativa ai fungicidi chimici.
Autore: La Redazione
©uvadatavola.com